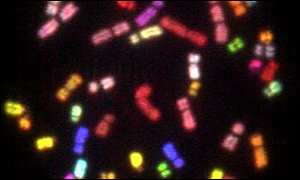

This is the time of rapid 'Eye', 'I', movement.
It will be 2005 in the blink of an Eye.

My metaphysical friends, most of who have been researching for decades, have come to the same conclusions I have. We have done our 'homework', networked within our community, media, lectured, completed the most important aspects of our work, and understand that All is 'out there' with nothing new. So many people...so much intense research to bring truth to the game for those who would learn from the efforts... truly a magnificent journey for those who know how to play on many levels.
Waiting Mode 2004.... Many people are bored. They are out there 'wading/waiting through the symbolism to find the answers. Remember that each soul must quest in their own time and manner as they are guided by their DNA. We all feel a sense of moving consciousness out of this experience. What is a person to do who is bored? Go out and play using the tools acquired while researching!
Whatever you do, don't preach to those who are not receptive nor ready, nor conscious beyond 3D. This is the year of DNA activation, when dwelling on issues leaves you wallowing in self-pity and the endless dramas of the physical realm. Physical reality is a never-ending story of challenges as we wonder why we are simply not shown the truths behind the illusion.
The Holy Grail

This is the Bloodline, those who created the program, encoding the truths in their DNA, who now awaken to bring about change as humanity comes full circle as the experiment ends.

The DNA Road Home
Twin Strands that Mirror Each Other, Duality, Polarity
Soul Mates - Separation and Reunion

The Road is Twisted

Zipper, Time Travel, Consciousness

Encoded DNA

The wheels/gears of synchronicity
The Experiment

The Coiling Snake, the Spirals

Consciousness spirals up and down
Higher=faster frequency of thought and light.

The beads, begin and end with white light, preset memory

The Canister, the Cylinders
The Time Capsules

'X', As is above, So is below
Merging at Zero Point

The Ladder, Jacob's Ladder, Earth to the Heavens

The Matrix, The Grid

The Lattice

The Bloodlines

Alchemy of Consciousness,
Physical DNA turns into Gold turns into Light

The Rollercoaster, The Bumpy Ride

Junk DNA - or is it?
Over 95% of our DNA has largely unknown functions but is a language.

DNA, Sacred Geometry, The Keys of the Bloodline

Infinity, Full Circle
For those who have recently crossed the threshold into higher awareness, raised their frequency vibration to a higher level of consciousness, just awakened, there are many courses of study to help guide your way. Your journey will move quickly as compared to those who began decades ago as 'the truth is out there', rediscovered by those who activated their DNA. It was their quest to rediscover the journeys home and set the groundwork for those who would follow.
Always remember that human DNA is not set up for 'full empowerment' until zero point no matter what you may conclude, because the human brain does not have the means to process what is above, at this level. A physical body, is a physical body and no one can spiral out of here physically and then return. Why? Because we are projected illusion in a game of consciousness and not created to understand beyond certain parameters. For now we are stuck in the game waiting for the final ending. Your powers return at the same time as does everyone else's, when we leave the physical, not a nano-second before.
The rest of the journey is still about '101 different ways to heal your issues' so you can remember and understand, that this is an experiment in time and emotion created by the patterns of sacred geometry. That's all there is! I know you've read it all here before, but do you understand it? 1010, the ON and OFF switches in a game of computer consciousness, where we play against the Trickster within each of us, the polarities of our emotions. I hope that 2004 brings love, health, happiness and some degree of fulfillment to your life. If you are in pain, I hope your burden lifts so you can heal and move into higher light with those who have overcome their obstacles and let go of fear and pain as their experience in the physical. Quest for your personal truths. This is a time of soul searching.
Here's something interesting you can do with a friend, either by phone or in person. Find a position that is comfortable for you. Close your eyes. Relax your mind and body, especially those shoulders and that jaw! Have the other person speak to you in a soft voice as if hypnotizing you ... telling you to relax. Then have the other person slowly whisper Your Name followed by the words "Wake up", or "Wake up, then your name .......Pause......Have them whisper it three times, pausing in between. What do you see? feel? experience?
Sleeping more these days? Feeling tired, droopy, disconnected?
You are not alone.
This appears to be is part of the process of awakening.
Time appears to be accelerating. It is the movement of energy spiraling upward as if a cone, as we return our consciousness to that which created it, Source, Home, Eye of God. Eye - Rods and Cones.
As the cones returned to the central circle, they locked into it as if keys.
Faster and faster we go, so hang on!

'Cone'y Island Roller Coaster...

You are here, in the box, because you came along for the ride, the roller coaster, that has its ups and downs as 'we', the innocent children, the emotional aspect of our souls, moves round and round until the ride 'ends.'

The Cones, The Eyes Have It!

The Eye, The Rods and the Cones.
Rods=Electromagnetic Energy, EM
Cones=Connections, to Source, Pyramid Energy

The Great Seal, Egyptian Mystery School Teachings

The 'All Seeing Eye', The Founding Fathers bring the secrets to the US
and leave us codes about a link between past, present and future.
'Source of Creation' is the Eye, the 'All Seeing Eye'

Eye of God
God is represented here as a single giant eye looking down from heaven with what appears
to be apocalyptic judgment yet the Eye sees the world as a whole, as a union of opposites.

The Voynich Manuscript which dates from the Middle Ages is encoded in an obscure language that has long baffled linguists. No one has been able to crack its code. Maybe that is just the point, codes, encoded DNA, etc. The pages of this manuscript are adorned with drawings, and curiously, one of these looks very much like a spiral arm map of the Milky Way, as seen looking down onto the Galactic plane from above, Thoth, As is Above, So is Below.

Ancient Egyptian myth describes mankind being punished by the Eye of Atum-Re (the Creator). In another myth it is the celestial Eye of Horus that brings destruction. You need destruction to have resurrection, not of Christ but of your soul.
I have been shown an End Time Scenario in which the sky opens in shades of mid-night blue, for All to see, the All Seeing Eye, I. A white light will appear. We are already being conditioned that we return to the white light when we leave here. In the Light each soul will see the projected image of the person they consider their savior, or want to be with when they leave the program. This helps souls overcome fear. You will actually be projecting this image with your mind. As with all 'below', all 'above' is about projected illusion, which shows us the way out and into our next experience. In higher consciousness you can project and manifest whatever you want, even this experience!
Eye, Eclipse Ancient Egypt Again
